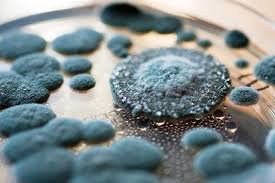
Giật mình vi khuẩn giết người trong mì

Nặng hơn, bệnh nhân có thể tử vong ngay sau khi ăn.
Thói quen ngâm mì thường thấy trong nhiều gia đình, tuy nhiên họ không hề biết rằng, hành động ấy vô tình khiến vi khuẩn lên men từ mì sẽ là tử thần đoạt mạng.
Vi khuẩn này phân hủy cùng các chất trong thực phẩm, tạo ra alatoxin và axit men gạo (mycolic acid). Chúng có thể phát triển từ 25-37 độ C và sinh ra lượng lớn axit men gạo.
Khuẩn pseudomonas cocotoxin sợ nhiệt, có thể tiêu diệt khi nấu nướng. Tuy nhiên, axit men gạo do chúng tạo ra có khả năng chịu nhiệt cao, không bị bất hoạt dù đun sôi đến 100 độ C hay ninh, nấu trong nồi áp suất lâu.
Chất độc này có thể gây ung thư khi tích tụ lâu ngày. Các nạn nhân có cùng triệu chứng nôn, tiêu chảy.
Tỷ lệ tử vong khi trúng độc từ 40 đến 100%.
Độc tố do pseudomonas cocotoxin sinh ra được các chuyên gia Trung Quốc phát hiện từ năm 1977. Loại độc này chủ yếu xuất hiện vào mùa hè, thu do thời tiết ẩm ướt, mưa nhiều, thực phẩm bị hư hỏng trong quá trình bảo quản.
Ngộ độc thường 30 phút sau khi ngộ độc hoặc có thể muộn nhất là 12 giờ.
Bệnh nhân ngộ độc thường đau bụng trên, buồn nôn, nôn, tiêu chảy, chóng mặt, suy nhược, nạn nhân bị vàng da, chướng gan, xuất huyết dưới da, nôn trớ, tiểu ra máu, bất tỉnh, co giật và sốc phản vệ.
Các bác sĩ khuyến cáo các sản phẩm ngũ cốc lên men (mì, hủ tiếu, bánh bao, bánh nếp/tẻ…), nấm, rất dễ nhiễm vi khuẩn pseudomonas cocotoxin, sau đó sinh ra độc tố.
Do đó, chúng ta cần cần trọng khi sử dụng các thực phẩm lên men. Nếu phát hiện các đốm mốc hồng, xanh lá cây, vàng, đen, chúng ta tuyệt đối không được sử dụng.
Sau khi ăn các ngũ cốc lên men, nếu bạn cảm thấy không khỏe hãy ngừng ăn ngay lập tức và tới bệnh viện kiểm tra. Khi có triệu chứng ngộ độc thực phẩm, chúng ta cần sơ cứu tạm thời bằng cách gây nôn càng sớm càng tốt.
Dù đã được sơ cứu ban đầu, bệnh nhân vẫn có thể gặp nguy hiểm bất cứ lúc nào. Do đó, chúng ta cần đưa nạn nhân tới bệnh viện, cơ sở y tế gần nhất.

Máy đếm tiền mini, máy đếm tiền chính hãng, máy đếm tiền giá bao nhiêu, mua máy đếm tiền, máy đếm tiền silicon, máy đếm tiền giá rẻ, máy đếm tiền ngân hàng, máy đếm tiền cầm tay, máy đếm tiền cũ, máy đếm tiền loại nào tốt, máy đếm tiền nhật bản, máy đếm tiền mini cầm tay, mua máy đếm tiền ở đâu, thanh lý máy đếm tiền, máy đếm tiền nhỏ gọn, máy đếm tiền mini giá bao nhiêu, máy khoan chứng từ, máy đếm tiền chất lượng cao, máy đếm tiền cao cấp, máy đếm tiền tại tphcm, máy đếm tiền xinda, máy đếm tiền xiudun